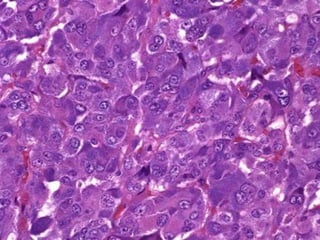

The document discusses the anatomy, embryology, histology, functions and pathologies of the adrenal glands. It covers the hormones produced by the adrenal cortex (cortisol, aldosterone) and medulla (epinephrine, norepinephrine), their roles and regulatory pathways. Key conditions discussed include Cushing's syndrome, Conn's syndrome, Addison's disease and pheochromocytoma. The synthesis, actions and metabolism of adrenal hormones are summarized along with tests used in diagnosis of adrenal disorders.






























![
CUSHINGS SYNDROME :
i]acth dependent
ii] non acth dependent
Acth dependent causes include
i]tumour of anterior pituitary
ii] tumour of lung secreting ACTH {ectopic acth secreting
tumour}
nonACTH dependent include
i]tumour in adrenal cortex
ii] iatrogenic(excessive medication by cortisol
analogues)
](https://image.slidesharecdn.com/completedseminar1-131225123847-phpapp02/85/ADRENAL-GLAND-31-320.jpg)





![ADDISONS DISEASE:bilateral destruction of adrenal
cortices .
causes are
i] tb
ii] autoimmune disorders
iii] fungal infection
iv] aids
There is destruction of all 3 layers
Loss of adrenocorticosteroids + excess of ACTH.
Signs&symptoms :low bp ,hypoglycemia
,intolerance to stress.
Lab findings :no rise plasma cortisol level after
ACTH injection.very low plasma cortisol level.high
levels of serum ACTH.
](https://image.slidesharecdn.com/completedseminar1-131225123847-phpapp02/85/ADRENAL-GLAND-37-320.jpg)